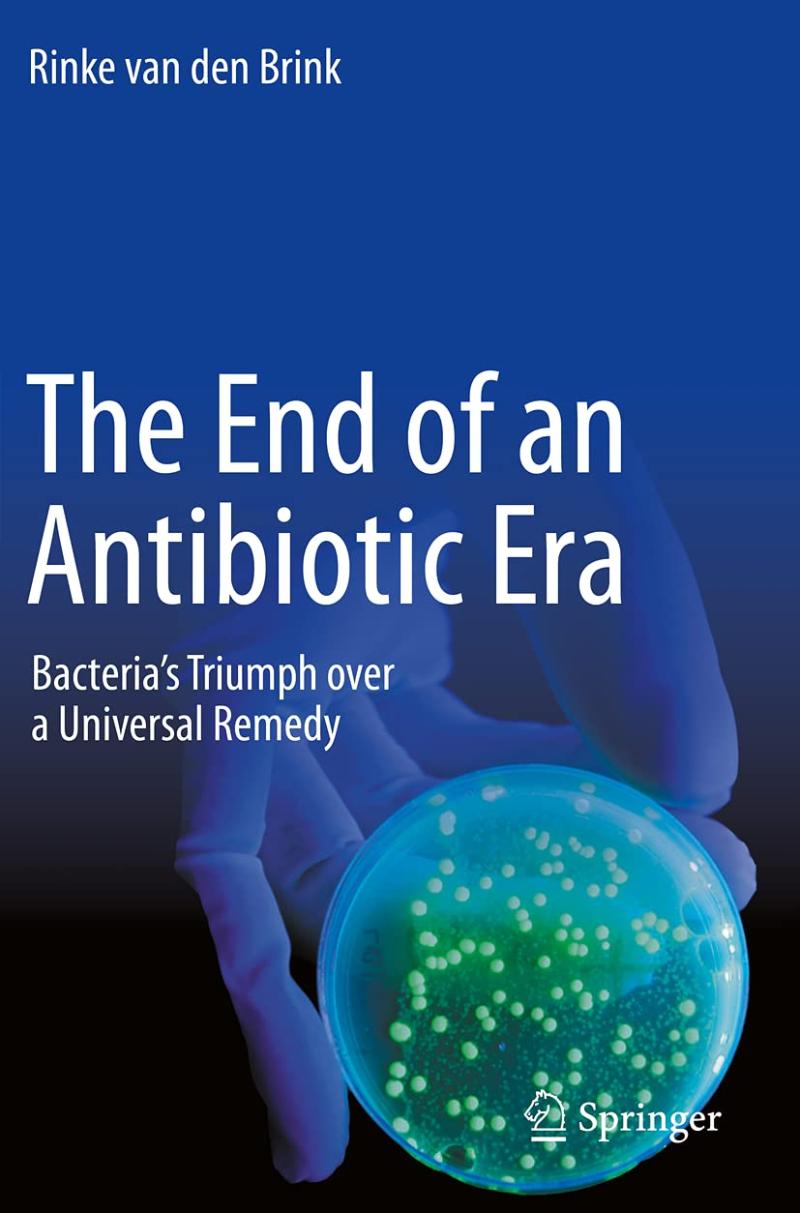

Bacteria are in the news more often than ever. Since a few years we're being swamped with reports about fatal outbursts. The Klebsiella bacteria in Maasstad hospital, for example, claimed the lives of at least three patients. The Q-fever made 25 casualties (the Dutch National Institute for Public Health and the Environment even talks about two or three times as many), the EHEC bacteria made fifty fatal victims in Germany and accounted for losses of hundreds of millions of Euros in the Dutch and European horticulture because the export nearly came to a standstill.
Antibiotics have long been a sort of wonder drug that allowed for a significant decrease in mortality from all kinds of infectious diseases. But there is one disadvantage to antibiotics: bacteria develop a resistance for them. In The End of Antibiotics journalist Rinke van den Brink puts these imperceptible bruisers under the microscope. He speaks with scores of international specialists and asks them for possible solutions, because antibiotic resistance is a worldwide problem.